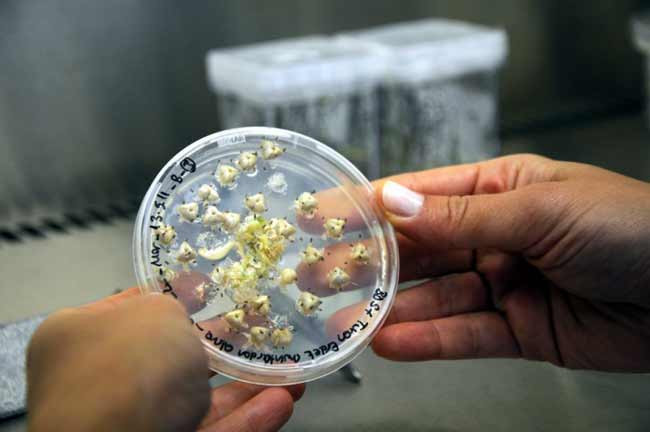
Türk bilimadamlarından dünyada bir ilk - Resim: 3

Türk bilimadamlarından dünyada bir ilk
|

Türkiye'de bilim adamları tarafından, dünyanın ilk tozlanma ve döllenme olmaksızın, sadece yumurta hücresinden saflaştırılmış pırasalar üretildi.

Türkiye'de bilim adamları tarafından, dünyanın ilk tozlanma ve döllenme olmaksızın, sadece yumurta hücresinden saflaştırılmış pırasalar üretildi.